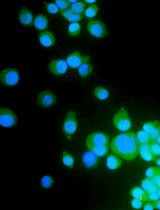

(*contributed equally to this work) Published: Vol 13, Iss 7, Apr 5, 2023 DOI: 10.21769/BioProtoc.4647 Views: 1520
Reviewed by: Oneil Girish BhalalaSrajan KapoorAnonymous reviewer(s)

Protocol Collections
Comprehensive collections of detailed, peer-reviewed protocols focusing on specific topics
Related protocols
Preparation, Characterization, and Cell Uptake of PLGA/PLA-PEG-FA Nanoparticles
Heng Yang [...] Didier Merlin
Apr 5, 2022 2732 Views

LIST: A Newly Developed Laser-assisted Cell Bioprinting Technology
Katiane Roversi [...] Christos Boutopoulos
Oct 5, 2022 1368 Views

Preparation and Characterization of Lipid Nanoparticles Co-loaded With DNA and Nitro-Oleic Acid
Manthan N. Patel [...] Jacob S. Brenner
Sep 20, 2025 1998 Views
Abstract
Interleukin-22 (IL-22) has been demonstrated as a critical regulator of epithelial homeostasis and repair; it showed an anti-inflammatory effect against ulcerative colitis. Local microinjection of IL-22 cDNA vector has been shown to be effective in treating ulcerative colitis in mouse models. However, microinjection comes with multiple technical challenges for routine colon-targeted drug delivery. In contrast, oral administration can get around these challenges and provide comparable efficacy. We showed in previous studies that oral administration of new lipid nanoparticles (nLNP)-encapsulated IL-22 mRNA targets the colon region and efficiently ameliorates colitis. This protocol describes the details of preparing and characterizing the nLNP-encapsulated IL-22 mRNA using three major lipids that mimic the natural ginger-derived nanoparticles. It provides an nLNP platform that can be used to orally deliver other types of nucleic acids to the colon.
Keywords: Ulcerative colitisBackground
Interleukin-22 (IL-22) is an anti-inflammatory cytokine that plays a critical role in promoting wound healing during intestinal inflammation. Its expression is decreased in inflamed ulcerative colitis tissue (De Souza and Fiocchi, 2016). Microinjection of IL-22 cDNA into the colon of colitic mice showed its potential in curing ulcerative colitis. Targeted delivery of IL-22 cDNA ameliorated local intestinal inflammation through induction of mucus production, enhancing STAT3 activation in colonic epithelial cells and promoting restitution of goblet cells. Additionally, inhibition of IL-22 activity suppressed goblet cell restitution during the recovery phase of the mouse model (Sugimoto et al., 2008).
Despite its effectiveness, microinjection is an invasive technique that requires trained personnel and specific medical equipment. Contrarily, oral delivery is noninvasive and more convenient for patient self-administration. Due to their excellent biocompatibility and drug-loading capability, nanostructured lipid carriers, such as solid lipid nanoparticles and liposomes, have become an attractive oral drug delivery platform that is starting to replace conventional drug delivery systems (Ahadian et al., 2020). However, challenges exist when the delivery system passes through the gastrointestinal tract, including high enzymatic activity and variation in pH and absorption efficiency across the intestinal epithelium.
We previously used ginger-derived lipid nanoparticles (GDNPs) for orally delivering CD98 siRNA (Zhang et al., 2017) and 6-shogaol (Yang et al., 2021) to treat ulcerative colitis. These studies suggested that GDNPs could overcome the challenges of oral drug delivery. Further, we found that monogalactosyl-diacylglycerol (MGDG), digalactosyl-diacylglycerol (DGDG), and phosphatidic acid (PA) constitute more than 90% of the total lipids of GDNPs (Zhang et al., 2016; Zhang et al., 2017). In this protocol, we will describe how to use these three lipids at the same ratios found in the GDNPs in the synthesis of new lipid nanoparticles (nLNPs) to encapsulate IL-22 mRNA. The nLNP-encapsulated mRNA showed its therapeutic efficacy in one of our recently published studies (Sung et al., 2022).
Materials and Reagents
50 mL single-neck recovery flask (Ace Glass, catalog number: 945808)
Micropipettes, 10–100 µL (Eppendorf, catalog number: 13-684-251)
Pipette tips, 1–300 µL (Fisher Scientific, SureOneTM micropoint pipette tips, catalog number: 02-707-410)
Serological pipettes, 5 mL (VWR, catalog number: 89130-886)
Disposable cuvettes (GMBH + Co KG, catalog number: 759075D)
Disposable folded capillary cell (Malvern, Zetasizer Nano Series, catalog number: DTS1070)
20% glucose solution (Gibco, catalog number: A2494001), stored at 4 °C
DEPC water (Invitrogen, catalog number: AM9916), stored at 4 °C
TurboFectTM transfection reagent (Thermo ScientificTM, catalog number: R0531), stored at 4 °C
Monogalactosyl-diacylglycerol (MGDG) (Avanti Polar Lipids, catalog number: 840523), stored at -20 °C
Digalactosyl-diacylglycerol (DGDG) (Avanti Polar Lipids, catalog number: 840524), stored at -20 °C
L-α-phosphatidic acid (PA) (Avanti Polar Lipids, catalog number: 840074), stored at -20 °C
IL-22 pMRNAXP vector (SBI, sequence XM_006513865.4), stored at -80 °C
mRNA synthesis kit (SBI, catalog number: MR-KIT-1), stored at -80 °C
200 proof ethanol (EtOH) (Decon Labs, catalog number: 2401); mix 350 mL of 100% EtOH with 150 mL autoclaved water for a solution of 70% EtOH
Dichloromethane (DCM) (Sigma, catalog number: 40042)
Equipment
Zetasizer Nano-ZS90 (Malvern Instruments Ltd., ZEN3690, serial number: MAL1181172)
Ultrasonicate cleaner (Branson Ultrasonics Corporation, Bransonic®, model: 3510R-MTH)
Rotary evaporator (BUCHI, model: R-210)
Vacuum pump (BUCHI, model: V-700)
Software
Zetasize software 7.12 Copyright© 2002-2016 (Malvern Instruments Ltd.)
Procedure
Equipment setup
Set the ultrasonic bath temperature to 50 °C prior to the start of the experiment.
Set the rotatory evaporator water bath temperature to 50 °C prior to the start of the experiment.
Clean all glassware with 70% EtOH followed by 100% EtOH.
Sanitize the vacuum hood with UV light for 1 h.
Preparation of lipid solutions
Add 2.5 mL of 100% EtOH to 5.0 mg of MGDG to make a 2.0 mg/mL MGDG solution.
Add 2.5 mL of 100% EtOH to 5.0 mg of DGDG to make a 2.0 mg/mL DGDG solution.
Add 5.0 mL of 100% dichloromethane (DCM) to 25.0 mg of PA to make a 5.0 mg/mL PA solution.
Keep the above solutions stored at -20 °C until use.
Synthesis of IL-22/nLNPs
Mix 99 μL of MGDG, 66 μL of DGDG, and 66 μL of PA solutions in a 50 mL single-neck recovery flask.
Add 2.5 mL of 100 % EtOH to the lipid mixture.
Swirl the flask to mix the lipids and the EtOH mixture.
Attach the flask to the rotary evaporator and rotate for 3–5 min at a 50 torr pressure (Figure 1).

Figure 1. Solvent evaporation by rotary evaporator
Release the vacuum when it reaches 50 torr pressure and transfer the flask to a UV-sanitized vacuum hood.
In a centrifuge tube, prepare a 5% glucose solution by mixing 1 mL of 20% glucose solution with 3 mL of RNase-free DEPC water.
Add 50 μL of in vitro transcription synthesized IL-22 mRNA (generated by using mRNA synthesis kit with custom designed IL-22 pMRNAXP vector as a template, following manufacturer’s instruction) and 50 μL TurboFectTM transfection reagent to the 500 μL of 5% glucose solution and mix. The total volume will be 600 μL.
Incubate the mixture for 15 min at room temperature.
Transfer the solution to the single-neck recovery flask containing the lipid mixture.
Place the bottom of the recovery flask in the water contained in the ultrasonic bath and pipette up and down (approximately 100 times) until the mixture becomes cloudy (Figure 2).
Store the prepared nLNPs at 4 °C.

Figure 2. Sonication of IL-22 mRNA and lipid mixture
Characterization of the nLNPs
Measure particle sizePlace approximately 1.5 mL of nLNPs suspension in a cuvette and cover it with a plastic cap.
Place the cuvette in the cuvette holder of Malvern Zetasizer.
Set the software function to measure the size.
Place approximately 1.0 mL of the nLNPs suspension in a capillary cell.
Place the cell in the cuvette holder of the Malvern Zetasizer.
Set the software function to measure the zeta potential.
Data analysis
Dynamic light scattering analysis showed that the average sizes for blank nLNPs (Figure 3) and IL-22/nLNPs (Figure 5) are 189.9 ± 69.3 and 184.2 ± 84.96 nm, respectively, based on triplicate measurement.
The zeta potential of blank nLNPs (Figure 4) and IL-22/nLNPs (Figure 6) are -5.51 ± 3.26 and -17.4 ± 7.63 mV, respectively, based on triplicate measurement.

Figure 3. Measurement of size in blank nLNPs. Particle size was determined to be 189.9 ± 69.3 nm in diameter.

Figure 4. Measurement of zeta potential in blank nLNPs. Surface zeta potential was measured as -5.51 ± 3.26 mV.

Figure 5. Measurement of size in IL-22/nLNPs. Particle size of IL-22/nLNPs was 184.2 ± 84.96 nm in diameter.

Figure 6. Measurement of zeta potential in IL-22/nLNPs. Surface zeta potential of IL-22/nLNPs was -17.4 ± 7.63.
Acknowledgments
This work was supported by the National Institute of Diabetes and Digestive and Kidney Diseases (NIDDK), grant numbers: RO1-DK-107739 (DM), RO1-DK-116306 (DM), and R01DK132891 (GA and SG). Department of Veterans Affairs (BX002526, DM). Dr. Merlin and Dr. Alpini are recipients of a Senior Research Career Scientist Award from the Department of Veterans Affairs.
Competing interests
The authors declare no conflicts of interest within the work.
References
Article Information
Copyright
© 2023 The Author(s); This is an open access article under the CC BY-NC license (https://creativecommons.org/licenses/by-nc/4.0/).
How to cite
Alghoul, Z., Sung, J., Wu, K., Alpini, G., Glaser, S., Yang, C. and Merlin, D. (2023). Preparation and Characterization of IL-22 mRNA-Loaded Lipid Nanoparticles. Bio-protocol 13(7): e4647. DOI: 10.21769/BioProtoc.4647.
Category
Biological Engineering > Biomedical engineering > Drug Delivery
Molecular Biology > Nanoparticle
Do you have any questions about this protocol?
Post your question to gather feedback from the community. We will also invite the authors of this article to respond.
Tips for asking effective questions
+ Description
Write a detailed description. Include all information that will help others answer your question including experimental processes, conditions, and relevant images.
Share
Bluesky
X
Copy link
